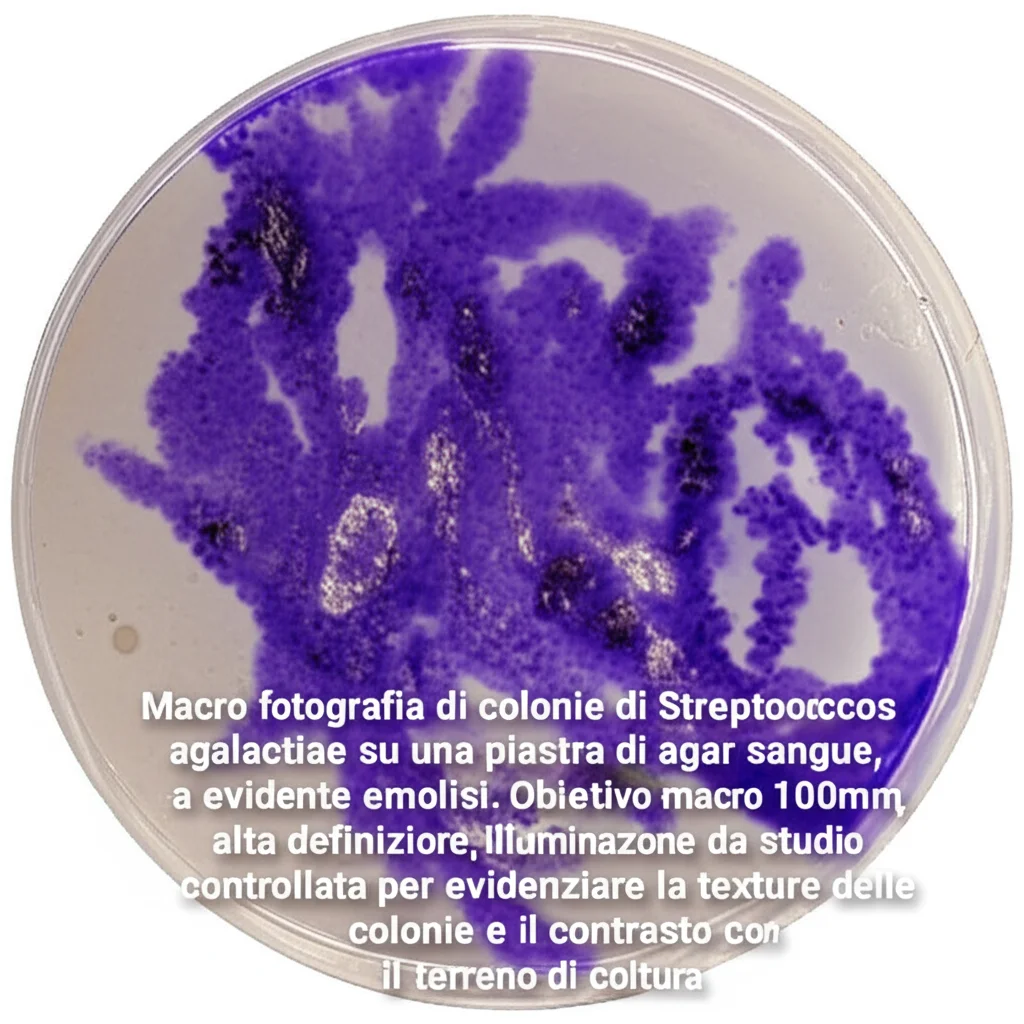
Macro fotografia di colonie di Streptococcus agalactiae su una piastra di agar sangue, con evidente emolisi. Obiettivo macro 100mm, alta definizione, illuminazione da studio controllata per evidenziare la texture delle colonie e il contrasto con il terreno di coltura.

Streptococcus agalactiae in Argentina: Viaggio nel DNA di un Nemico Nascosto nelle Stalle
Amici allevatori e appassionati di scienza, oggi vi porto con me in un’indagine affascinante che tocca da vicino il mondo della zootecnia e, in particolare, la salute delle nostre mucche da latte. Parliamo di un problema serio, la mastite bovina, un’infiammazione della mammella che non solo fa soffrire gli animali, ma riduce anche la qualità e la quantità del latte prodotto, causando perdite economiche non da poco. E chi è spesso il colpevole dietro le quinte? Un batterio dal nome un po’ altisonante: lo Streptococcus agalactiae.
Chi è questo Streptococcus agalactiae? Un identikit del batterio
Immaginatevi questo Streptococcus agalactiae (chiamiamolo S. agalactiae per gli amici) come un batterio Gram-positivo, un tipetto piuttosto contagioso che può causare mastiti sia cliniche (quelle evidenti) sia subcliniche (più subdole, ma altrettanto dannose). Il bello è che questo batterio è un osso duro: può sopravvivere a lungo all’interno della mammella e, come abbiamo scoperto più di recente, anche in fonti esterne alla mammella stessa. E non è tutto: c’è il sospetto, anzi, più di un sospetto, che possa passare dalle mucche agli umani e viceversa. Sì, avete capito bene, è considerato un patogeno zoonotico, il che rende la faccenda ancora più seria.
Quando ci si trova di fronte a un’infezione da S. agalactiae in una mandria, la strategia principale è la terapia antimicrobica. La penicillina è stata per anni la prima scelta, ma ahimè, come spesso accade, sono emersi ceppi meno sensibili. Si è quindi passati ad alternative come macrolidi e lincosamidi, ma anche qui la resistenza sta diventando un problema globale. Pensate che alcuni isolati poco sensibili alla penicillina mostrano resistenza anche ad altri antibiotici, diventando dei veri e propri “superbatteri” multi-resistenti. La resistenza antimicrobica è una preoccupazione enorme, sia in medicina veterinaria che umana, non mi stancherò mai di dirlo!
Per capire come si diffonde e come combatterlo, è fondamentale caratterizzare i ceppi batterici e monitorare l’evoluzione della loro resistenza. Nello S. agalactiae, abbiamo identificato geni di resistenza come erm, lnuB, tet, e aphA3/aad6, coinvolti nella resistenza a macrolidi, lincosamidi, tetracicline e aminoglicosidi.
I “superpoteri” del batterio: i fattori di virulenza
Ma come fa questo batterio a essere così efficace nel causare l’infezione? Grazie ai suoi fattori di virulenza. Immaginateli come degli “strumenti” speciali che permettono al batterio di colonizzare, invadere le barriere epiteliali, sfuggire al sistema immunitario e persistere nei tessuti dell’ospite. Tra questi, troviamo il polisaccaride capsulare (codificato da cpsA), che è un po’ il suo scudo anti-fagocitosi, e proteine di superficie che lo aiutano ad aderire e invadere, come la C5a peptidasi (scpB), la proteina α-C (bca), la proteina β-C (bac), Rib (rib) e la proteina legante la laminina (lmb). Produce anche tossine ed enzimi, come quello codificato dal gene cylE, che possono formare pori e danneggiare i tessuti. E non dimentichiamo l’hylB, una ialuronidasi che facilita la diffusione del batterio. Infine, ci sono i pili, strutture simili a peli che promuovono l’adesione alle cellule ospiti, codificati da loci chiamati PI-1 e PI-2 (con varianti PI-2a e PI-2b).
In base alle differenze nel polisaccaride capsulare (CPS), lo S. agalactiae si classifica in 10 sierotipi (Ia, Ib, II, III, IV, V, VI, VII, VIII, IX), ma questa classificazione da sola non basta per distinguere bene i vari isolati. Per questo, si usano metodi di subtipizzazione più potenti, come l’analisi del polimorfismo dei frammenti di restrizione (PFGE) o, ancora meglio, l’analisi del numero variabile di tandem repeats in loci multipli, la famosa MLVA (Multiple Locus Variable number tandem repeat Analysis). La MLVA è più veloce e ha una maggiore risoluzione, identificando variazioni nel numero di sequenze ripetute in tandem in diversi punti del genoma batterico. È come creare una carta d’identità genetica molto dettagliata.
La nostra indagine in Argentina: cosa abbiamo scoperto?
E qui veniamo al cuore della nostra ricerca. Ci siamo chiesti: qual è la diversità genetica dello S. agalactiae isolato da mucche con mastite negli allevamenti argentini? Per scoprirlo, abbiamo analizzato 87 isolati di S. agalactiae provenienti da allevamenti situati in una delle più grandi regioni produttrici di latte dell’Argentina. Abbiamo usato un arsenale di tecniche: MLVA, analisi dei sierotipi, dei fattori di virulenza (VF) e dei profili di resistenza antimicrobica (AMR). L’obiettivo era anche confrontare il potere discriminante di questi metodi, usati singolarmente o in combinazione.
I risultati sono stati illuminanti!
- I sierotipi più comuni erano il III (nel 63.2% dei casi), seguito dal II (26.4%) e dall’Ia (5.8%). Una piccola percentuale (4.6%) non era tipizzabile.
- Parlando di geni di virulenza, cpsA e hylB erano presenti nel 100% degli isolati – dei veri e propri “must-have” per questo batterio! Subito dopo, il gene del pilus PI-2b (93%) e cylE (89%). È interessante notare che la variante del pilus PI-2b è spesso associata agli isolati bovini. Altri geni come bac, lmb, scpB, hvgA e i pili PI-1/PI-2a non sono stati trovati in nessun isolato, confermando che sono più tipici degli isolati umani.
- Per quanto riguarda i geni di resistenza antimicrobica, tetO (resistenza alle tetracicline) e ermB (resistenza a macrolidi e lincosamidi) erano i più frequenti, rilevati rispettivamente nel 64% e nel 54% degli isolati.
Quando abbiamo combinato i dati sui fattori di virulenza (VF) e sulla resistenza antimicrobica (AMR), abbiamo identificato ben 36 profili genetici diversi, con un potere discriminante (Ds) del metodo pari a 0.96. Un ottimo risultato!
MLVA: la carta d’identità genetica
L’analisi MLVA, basata su sei VNTR (SAG2, SAG3, SAG4, SAG7, SAG21, SAG22), ci ha rivelato 29 profili genetici distinti, con un indice di diversità di Simpson (Ds) di 0.90. Questo indica una notevole diversità genetica tra gli isolati bovini argentini. Pensate che altri studi su ceppi umani hanno ottenuto valori di Ds leggermente inferiori, il che potrebbe suggerire che gli isolati bovini sono più diversificati per quanto riguarda questi loci VNTR.
L’allevamento A, con 28 isolati raccolti tra il 2017 e il 2018, ha mostrato la maggiore diversità di profili MLVA (ben 11!), seguito dall’allevamento B. Abbiamo anche trovato profili MLVA condivisi tra isolati di allevamenti diversi, il che non sorprende più di tanto. In Argentina, infatti, non è raro che gli allevatori spostino o commercino mucche da latte, e questo facilita la trasmissione di S. agalactiae tra le aziende. Ad esempio, sappiamo che c’è stato uno scambio di bestiame tra gli allevamenti A e B, il che spiega perché condividessero alcuni profili.
Ma la vera magia si è vista quando abbiamo messo insieme tutti i dati: VF + AMR + MLVA. Il potere discriminante è schizzato a 0.98, permettendoci di identificare ben 59 profili genetici! Questo ci dice chiaramente che la MLVA è uno strumento preziosissimo da aggiungere ad altre metodologie per studiare le relazioni epidemiologiche tra i ceppi di S. agalactiae.

Implicazioni e segreti svelati
Questa ricerca ci ha svelato alcuni segreti interessanti. Anche se all’interno di ogni allevamento c’era una predominanza di certi sierotipi o profili di virulenza, le caratteristiche non erano totalmente omogenee. Questo, come dicevo, suggerisce l’introduzione di animali da altre mandrie, una pratica comune. D’altra parte, il rilevamento dello stesso clone (o ceppo batterico) nello stesso allevamento in periodi diversi conferma che i ceppi di S. agalactiae possono persistere negli allevamenti per molto tempo, nel nostro studio anche più di un anno! Questo significa che le infezioni possono diventare subcliniche e rimanere lì, pronte a riesplodere.
Abbiamo anche fatto delle analisi di correlazione. Ad esempio, l’allevamento J era fortemente correlato negativamente con il gene spb1 e positivamente con aad6 (un gene di resistenza agli aminoglicosidi), oltre che con ermB e tetO, e negativamente con cylE. Queste associazioni specifiche tra geni, profili MLVA e allevamenti potrebbero essere la chiave per capire meglio come si diffonde l’infezione e come si sviluppa la resistenza.
Cosa ci portiamo a casa?
Questo studio sottolinea quanto sia importante usare un approccio combinato per studiare la diversità genetica di patogeni come lo S. agalactiae. La MLVA si è dimostrata uno strumento potente, soprattutto se integrata con dati sui fattori di virulenza e sulla resistenza antimicrobica. Comprendere la genetica di questi batteri, come si muovono tra gli allevamenti e come persistono nel tempo, è fondamentale per sviluppare strategie di controllo e prevenzione più efficaci nel settore lattiero-caseario argentino. La lotta contro la mastite bovina è complessa, ma ogni nuova informazione che riusciamo a carpire dal DNA di questi microrganismi ci avvicina un po’ di più alla soluzione. E questo, amici miei, è il bello della ricerca scientifica!
Fonte: Springer
